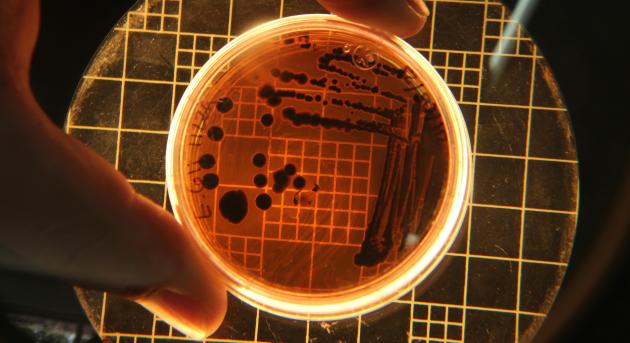
Végre valami hasznosat csinált az MI

Végre valami hasznosat csinált az MI
Egy stanfordi tudóscsapat képek rajzfilmesített változata helyett inkább baktériumölő vírusokat terveztetett meg az algoritmussal. A jelek szerint teljes sikerrel.
Hamarosan átirányítunk a teljes cikkhez → Bitport